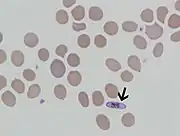

Plasmodium falciparum
Plasmodium falciparum (лат. falc — серп і лат. parere — народити) — вид паразитичних найпростіших, які є збудниками тропічної малярії. Передається людині при укусах комарів роду Anopheles. Існує велика кількість географічних штамів цього плазмодія.
? Plasmodium falciparum | ||||||||||||||||
|---|---|---|---|---|---|---|---|---|---|---|---|---|---|---|---|---|
![]() Мазок крові з гамонтами Plasmodium falciparum між еритроцитами | ||||||||||||||||
| Біологічна класифікація | ||||||||||||||||
| ||||||||||||||||
Посилання | ||||||||||||||||
| ||||||||||||||||
Особливості життєвого циклу і будова
У циклі розвитку плазмодіїв відбувається чергування:
- безстатеве розмноження шляхом множинного поділу (шизогонія), яке в свою чергу має 2 стадії, що йдуть послідовно:
- тканинна (відбувається в печінці людини),
- еритроцитарна;
- статевий розвиток (спорогонія), який відбувається в організмі комара роду Anopheles.
Детальніші відомості з цієї теми ви можете знайти в статті Плазмодій.

Тканинна шизогонія
Експериментальне дослідження тканинної стадії в людини та шимпанзе показало, що цей вид малярії людини відрізняється від P. vivax і P. ovale в тому, що екзоеритроцитарний цикл обмежується єдиним поколінням, тобто немає тканинних шизонтів-гіпнозоїтів. Тканинний цикл Plasmodium falciparum вперше було продемонстровано у 1949—1951 роках у біоптатах печінки, отриманих від добровольця, який був укушений 770 комарами Anopheles (з 93 % їхнього інфікування) протягом 3 днів. 4-денні шизонти описуються як яйцеподібні або сферичні за формою, з певною тенденцією до дольчастості. П'ятиденні шизонти сягали приблизно 50 мкм у найдовшому вимірі. Тенденція до дольчастості була більш вираженою. Гепатоцит не мав патоморфологічної реакції на шизонта. Було виявлене розділення цитоплазми на області, що нагадують цитомери. Ці псевдоцитомери варіювалися від сферичної до подовжньої форми. Кожен містив велику кількість ядер. Розмір окремих ядер у активному розподілі становив приблизно 0,8 мкм. Мембрана навколо паразитів була менш очевидною ніж у 4-денного шизонта. Шестиденний шизонт зазнає дуже швидкого росту, розростаючись нерівномірно у багатьох напрямках. Він завдовжки від 50 до 60 мкм і характеризується більшою деформацією ніж P. vivax, через виражену тенденцію до утворення часток. Кількість ядер суттєво зростає, цитоплазма густо засіяна ними. На цьому етапі паразит, як видається, розпадається зрештою на маленькі острівці цитоплазми, розміром приблизно 2 мкм у діаметрі, кожен острівець містив по два дуже маленьких ядра. Наприкінці зрілий тканинний шизонт (морула) сягає 60 мкм або більше, що містить велику кількість мерозоїтів. Кожен мерозоїт, діаметром близько 0,7 мкм, складається з ядра з слідами цитоплазми. Кількість мерозоїтів дорівнює приблизно 40 000.
Еритроцитарна шизогонія
Було продемонстровано, що препатентний період (термін від моменту зараження після укусу комара до моменту впровадження в еритроцит) сягає 6 днів.
Наймолодші «персневі» форми Plasmodium falciparum в еритроциті менші за розміром, ніж в інших збудників людської малярії і зазвичай нагадують звернуте в кільце волосся, з вакуолею і виразним ядром. Іноді видно додаткову точку хроматину. Одночасне вторгнення до еритроциту хазяїна кількох плазмодіїв частіше зустрічається при даному виді, ніж в інших малярійних паразитів людини. Було писано навіть 7-8 персневих форм в одному еритроциті. Аплікаційні форми є частими і, отже, їхнє виявлення має певну діагностичну цінність. У міру розвитку збільшується загальний розмір паразита, вакуоль та ядро його стають більш помітними, і можуть з'явитися стрічкові форми. Окрім цих ненормальних форм, немає помітної амебоїдності. Паразит надалі стає меншим і компактнішим, цитоплазма забарвлюється у яскравий синій колір. Далі втрачається вакуоль, ядро перестає бути округлим, а в цитоплазмі з'являються темні пігментні зерна. На цьому етапі кількість плазмодіїв у периферичній крові зменшується через їхню схильність до затримання у капілярах внутрішніх органів, особливо головного мозку, властивість, спільну з Plasmodium coatneyi, тож, у неускладнених випадках хвороби в периферичній крові іноді важко знайти пізні форми Plasmodium falciparum. Разом з цим часто еритроцитарна шизогонія носить асинхронний характер через зараження різними лініями цього плазмодія, які проходять свої цикли в різний час. Особливістю еритроцитарної шизогонії Plasmodium falciparum є те, що значне накопичення плазмодіїв в капілярах внутрішніх органів призводить до зменшення або, навіть, припинення кровотку там, через що пізні генерації не можуть туди продертися і їхня еритроцитарна шизогонія вже відбувається у периферичних кровоносних судинах. Це йде разом з тяжкими ускладненнями малярії, отже виявлення в периферичній крові усіх форм трофозоїтів і шизонтів часто свідчить про тяжкий, ускладнений перебіг тропічної малярії. Хоча можливі ситуації, коли клінічні прояви у хворого не є тяжкими, але у периферичній крові спостерігають високий рівень паразитемії разом із появою усіх форм плазмодія.
Під час шизогонії ядро неодноразово ділиться, плазмодій збільшується в розмірах, допоки він не займе більшу частину еритроцита. Спочатку пігмент збирається у невеликих агрегаціях, але, коли плазмодій визріває, то пігмент збирається в одну жовтувато-коричневу масу. Зрілий шизонт Plasmodium falciparum менш симетричний, ніж інші плазмодії малярії людини і всередині його постають мерозоїти від 8 до 20, але в середньому їх близько 16.
Однією з яскравих особливостей еритроцитів, інфікованих безстатевими формами цього плазмодія, є ранній розвиток пігментної плямистості Маурера. Її структури, що нагадують волосся, з'являються вже на ранній кільцевій стадії шизогонії. Коли плазмодій надалі розвивається, ці структури стають більш вираженими. Вони виявляються в еритроцитах, заражених плазмодієм, лише за певних процедур фарбування, які не входять до рутинного набору фарб для діагностики малярії.
Зрілі гаметоцити (статеві клітини) є унікальними серед плазмодієв людської малярії через їхню унікальну серпоподібну або форму півмісяця. У більшості малярійних плазмодієв гаметоцити з'являються у периферичній крові приблизно в той самий час, що й еритроцитарні мерозоїти, тоді як у Plasmodium falciparum це відбувається приблизно через 10 днів від закінчення першого циклу еритроцитарної шизогонії. Молоді гаметоцити ростуть у крові судин селезінки та кісткового мозку. Макрогаметоцит (жіноча клітина) є відносно тонким, має гострі кінці, й, як правило, довший за розмірами, ніж мікрогаметоціт (чоловіча клітина). Цитоплазма забарвлюється чітким синім кольором. Ядро компактне і може бути замасковане пігментними гранулами, які, як видається, покривають його. Еритроцит виглядає розтягненим макрогематоцитом. Мікрогаметоціти сосископодібної форми з тупими закругленими кінцями. Цитоплазма забарвлюється світло-блакитно-фіолетовою. Ядро займає близько половини загальної довжини паразита. Еритроцитарна шизогонія триває 48 годин.
Спорогонія
Чорні пігментні гранули (від 10 до 20 у кількості), як правило, появлялися в ооцисті між 3-7 днями її розвитку в подвійному півколі по периферії ооциста. На 8-й день пігмент вже не спостерігали. Ооцисти були від 8 до 60 мкм у діаметрі. Спорогонічний цикл тривав 11-12 днів. З 3-го по 5-й день щоденне збільшення діаметра ооциста становило приблизно 4 мкм. З 6-го по 10-й день щоденне збільшення зростало і становило близько 10 мкм. Інфективні спорозоїти з'являлись у слинних залозах комарів на 14 добу від початку спорогонії. Було встановлено, що ефективна спорогонія Plasmodium falciparum відбувається щонайменше у 66 видів комарів роду Anopheles.
Поширення в природі
Plasmodium falciparum, який спричинює тропічну малярію, загалом поширений в країнах тропічного і субтропічного кліматичного поясу, географічний ареал стабільно знаходиться між 40° північної широти і 20° південної широти, хоча в певних умовах можливе просування збудника і північніше у помірні широти, аж до 61° північної широти. Поширення цього виду плазмодія в країнах тропічного і субтропічного кліматичного поясу пояснюється тим, що у P. falciparum не виявлено біологічних властивостей, які мали б пристосувальний характер до існування поза межами жаркого клімату. Однак, в екваторіальній зоні Південної Америки за широтою розподілу P. falciparum в два рази поступається P. vivax. Близько 40 видів комарів роду Anopheles здатні передавати P. falciparum і, відповідно, поширювати тропічну малярію. Разом з тим, численні дослідження показують, що стійка передача в Європі тропічної малярії неможлива через те, що місцеві комарі не можуть переносити P. falciparum. Дослідження показали, що в Україні автохтонні види Anopheles не здатні заражатися гамонтами P. falciparum, а тропічні види комарів, здатні переносити гамонти збудника тропічної малярії, не виживають у нас через відносну низьку температуру довкілля, в зв'язку з чим тропічна малярія в нашій країні на сьогоднішній день ендемічно закріпитися не зможе. Однак прогресуючі кліматичні зміни на тлі глобального потепління, можуть сприяти появі на півдні Європи виду Anopheles superpictus, що створює умови для місцевої передачі P. falciparum.
Клінічні особливості тропічної малярії
Як правило при цьому виді людської малярії через особливості розвитку плазмодіїв у капілярах внутрішніх органів розвивається тяжкі форми з ураженням центральної нервової системи — церебральна форма, інші тяжкі ускладнення. Через це найбільша кількість смертей припадає саме на тропічну малярію — до 98 %. Серед особливостей її практична відсутність ініціальної гарячки, значний рівень ураження еритроцитів, що призводить до тяжкої анемії.
Детальніші відомості з цієї теми ви можете знайти в статті Малярія.
Примітки
- Супергрупа найпростіших (англ. Stramenopiles + Alveolata + Rhizaria). Adl S. M., Simpson A. G., Lane C. E., Lukeš J., Bass D., Bowser S. S., Brown M. W., Burki F., Dunthorn M., Hampl V., Heiss A., Hoppenrath M., Lara E., Le Gall L., Lynn D. H., McManus H., Mitchell E. A., Mozley-Stanridge S. E, Parfrey L. W., Pawlowski J., Rueckert S., Shadwick R. S., Schoch C. L., Smirnov A., Spiegel F. W. The revised classification of eukaryotes // The Journal of Eukaryotic Microbiology. — 2012. — Vol. 59, no. 5. — P. 429—493. — DOI:10.1111/j.1550-7408.2012.00644.x. — PMID 230202 (англ.)
Див. також
Джерела
- Голубовская О. А., Шкурба А. В., Колос Л. А. Малярия: монография К. : ВСИ «Медицина», 2015. — 288 с., в тому числі 32 с. цв. вкл. ISBN 978-617-505-419-2
- «Malaria Fact Sheet». World Health Organization. Updated April 2017. (англ.)
- Coatney GR, Collins WE, Warren M, Contacos PG. The Primate Malarias. US Department of Health, Education and Welfare, Bethesda. 1971. chap. 22. (англ.)
Література
- Gardner, M.J.; Hall, N.; Fung, E.; White, O.; Berriman, M.; Hyman, R.W.; Carlton, J.M.; Pain, A.; Nelson, K.E.; Bowman, S.; Others, (2002). Genome sequence of the human malaria parasite Plasmodium falciparum. Nature 419 (6906): 498–511. Bibcode:2002Natur.419..498G. PMID 12368864. doi:10.1038/nature01097.
- Allison AC (February 1954). Protection Afforded by Sickle-cell Trait Against Subtertian Malarial Infection. Br Med J 1 (4857): 290–4. PMC 2093356. PMID 13115700. doi:10.1136/bmj.1.4857.290.
- Mockenhaupt FP, Ehrhardt S, Otchwemah R, et al. (May 2004). Limited influence of haemoglobin variants on Plasmodium falciparum msp1 and msp2 alleles in symptomatic malaria. Trans. R. Soc. Trop. Med. Hyg. 98 (5): 302–10. PMID 15109555. doi:10.1016/j.trstmh.2003.10.001.
